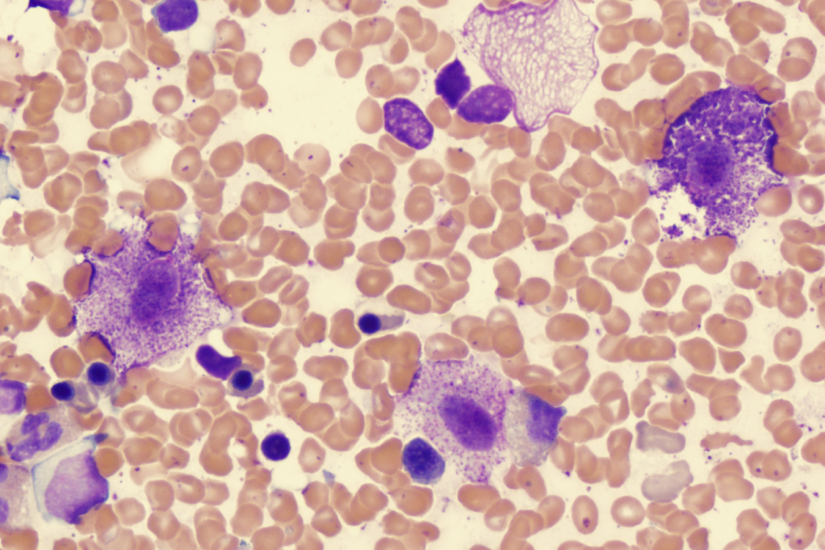
Mastocite

Contactează-ne!
Ai simptome care te supără? Solicită chiar acum un sfat medical specializat.
Ce trebuie să știi acum despre mastocitoză:
- Mastocitoza este o boală rară caracterizată prin acumularea excesivă și anormală de mastocite (celule ale sistemului imunitar) în piele sau în diverse organe interne.
- Există două forme principale: mastocitoza cutanată, care afectează doar pielea (frecventă la copii), și mastocitoza sistemică, ce implică organele interne (frecventă la adulți).
- Simptomele sunt declanșate de eliberarea mediatorilor chimici (precum histamina) și pot varia de la erupții cutanate și dureri abdominale până la șoc anafilactic.
- Managementul bolii se concentrează pe evitarea factorilor declanșatori, regim alimentar specific și tratament medicamentos pentru controlul simptomelor.
Citește în continuare articolul pentru a înțelege cum poți gestiona eficient mastocitoza și care sunt pașii necesari pentru un diagnostic de precizie.
- Ce este mastocitoza și de ce este important diagnosticul precoce?
- Câte tipuri de mastocitoză există?
- Diagnosticul mastocitozei: biopsie, analize și testarea mutației KIT
- Managementul și tratamentul mastocitozei
- Rolul alimentației în viața pacienților cu mastocitoză: tabel cu alimente interzise și permise
- Ce pași concreți ai de făcut acum?
- Întrebări frecvente despre mastocitoză
Ce este mastocitoza și de ce este important diagnosticul precoce?
Mastocitoza reprezintă o tulburare rară în care organismul produce prea multe mastocite, celulele care joacă un rol cheie în reacțiile alergice.Spre deosebire de alergiile obișnuite, în mastocitoză, mastocitele sunt într-o stare de alertă permanentă. Atunci când se acumulează în număr mare, ele pot elibera histamină, chiar si sub influența unor stimuli banali (frecare, caldura, stres, etc) sau în absența oricărui factor declansator, provocând inflamații acute în organism.
Identificarea timpurie a bolii este crucială deoarece simptomele pot imita alte afecțiuni comune, cum ar fi alergiile alimentare sau bolile gastrointestinale. Un diagnostic precoce permite stabilirea unui plan de urgență pentru prevenirea anafilaxiei și protejarea organelor care pot fi afectate de infiltrarea celulară masivă.
Câte tipuri de mastocitoză există?
Clasificarea mastocitozei depinde de locul în care s-au acumulat celulele anormale. Deși mecanismul de bază este similar, manifestările și prognosticul diferă considerabil între formele care afectează strict pielea și cele care se răspândesc în întregul sistem.
Care sunt simptomele mastocitozei cutanate?
Mastocitoza cutanată se manifestă cel mai adesea prin prezența unor pete mici, de culoare maroniu-roșcată, distribuite pe corp. Aceste leziuni pot provoca mâncărimi intense și se pot transforma în vezicule, în special la copiii mici.
Un semn caracteristic utilizat în diagnostic este semnul Darier. Acesta constă în umflarea și înroșirea rapidă a unei pete atunci când este frecată ușor, din cauza eliberării locale de histamină din mastocite. Această reacție cutanată este un indicator clinic puternic pentru prezența bolii.
Care sunt simptomele mastocitozei sistemice?
În formele sistemice, mastocitele se infiltrează în organe, provocând simptome care pot afecta calitatea vieții și pot deveni amenințătoare. Pacienții pot experimenta înroșirea bruscă a feței și gâtului, însoțită de scăderea tensiunii arteriale.
Manifestările includ:
- Probleme digestive: dureri abdominale, diaree cronică, greață și episoade de ulcer gastric.
- Afectare osoasă: dureri de oase și un risc crescut de osteoporoză precoce din cauza infiltrării măduvei.
- Șoc anafilactic: reacții alergice severe care pot apărea brusc la înțepături de insecte sau anumite alimente.
- Tulburări cognitive: dificultăți de concentrare, oboseală cronică sau schimbări de dispoziție (anxietate, iritabilitate).
👉 Recunoști unele manifestări? Programează o consultație alergologică la REGINA MARIA, singurul furnizor privat cu cinci spitale acreditate internațional, pentru a investiga cauza reacțiilor tale cutanate sau sistemice.


Diagnosticul mastocitozei: biopsie, analize și testarea mutației KIT
Stabilirea unui diagnostic cert în mastocitoză este un proces riguros care necesită confirmare prin teste de laborator și evaluări histopatologice. Deoarece simptomele pot fi confundate cu alte reacții alergice, medicii apelează la investigații specifice care măsoară încărcătura de mastocite din organism.
La REGINA MARIA, procesul de diagnosticare beneficiază de tehnologie avansată și de colaborarea unei echipe multidisciplinare. Testele fundamentale includ:
- Dozarea triptazei serice: o analiză de sânge care măsoară nivelul unei enzime eliberate de mastocite; valori constant ridicate sugerează o formă sistemică.
- Biopsia cutanată: recoltarea unei mici mostre de piele pentru examinare la microscop, esențială pentru confirmarea mastocitozei cutanate.
👉 Află cât durează până primești rezultatul biopsiei cutanate și cum te pregătești pentru recoltare.
- Biopsia de măduvă osoasă: procedura standard pentru diagnosticul mastocitozei sistemice la adulți, permițând vizualizarea agregatelor de mastocite.
- Analiza genetică pentru mutația KIT (D816V): identificarea acestei mutații specifice în celulele afectate ajută la confirmarea diagnosticului și la ghidarea tratamentului.
👉 Programează o consultație dermatologică la REGINA MARIA, lider în calitatea serviciilor medicale, pentru evaluarea oricărei leziuni suspecte și pentru efectuarea unei biopsii cu rezultate rapide.
REGINA MARIA este rețeaua de sănătate care conduce transformarea digitală în domeniul medical din România, prin investiții constante în tehnologie de ultimă generație și AI. Rețeaua oferă pacienților acces la laboratoare inteligente, echipate cu cele mai noi tehnologii și integrate într-un sistem național performant.
Laboratoarele REGINA MARIA sunt primele din țară acreditate RENAR pentru utilizarea inteligenței artificiale și sunt recunoscute pentru acuratețea și siguranța rezultatelor, eliberarea rapidă a analizelor, aparatură de ultimă generație și o gamă completă de teste genetice și analize medicale.

Managementul și tratamentul mastocitozei
Deși în prezent nu există o metodă de vindecare definitivă pentru mastocitoză, tratamentul modern se concentrează pe controlul simptomelor și prevenirea eliberării masive de mediatori chimici. Obiectivul principal este îmbunătățirea calității vieții și evitarea episoadelor de anafilaxie. Strategiile de tratament și gestionare includ:
- Antihistaminice (blocante H1 și H2): utilizate pentru a reduce mâncărimea, înroșirea pielii și simptomele gastrointestinale.
- Stabilizatori ai mastocitelor: substanțe precum cromoglicatul de sodiu care ajută la prevenirea eliberării mediatorilor din celule.
- Corticosteroizi topici sau sistemici: utilizați pentru controlul inflamației severe în perioadele de acutizare a bolii.
- Adrenalina autoinjectabilă: esențială pentru pacienții cu risc de șoc anafilactic, fiind o măsură de siguranță vitală.
- Fototerapia (PUVA): utilă în formele de mastocitoză cutanată pentru a reduce aspectul leziunilor și pruritul.
- Terapii țintite: medicamente noi care vizează direct mutația KIT în formele agresive de boală.
👉 Citește și: Șocul anafilactic – Ce este? Simptome, cauze și tratament.

Rolul alimentației în viața pacienților cu mastocitoză: tabel cu alimente interzise și permise
Alimentația joacă un rol crucial în gestionarea mastocitozei, deoarece multe alimente pot declanșa eliberarea de histamină din mastocite sau conțin ele însele niveluri ridicate de histamină. O dietă hipohistaminică nu vindecă boala, dar reduce semnificativ „povara” simptomatică, diminuând frecvența episoadelor de flushing, a durerilor abdominale și a mâncărimilor cutanate.
Principiul de bază al acestei diete este prospețimea. Histamina se acumulează în alimente pe măsură ce acestea sunt depozitate sau procesate prin fermentare și maturare. Din acest motiv, pacienții cu mastocitoză sunt sfătuiți să consume alimente cât mai puțin procesate și să evite semipreparatele sau alimentele reîncălzite. Iată un tabel cu recomadări alimentare utile.

Ce pași concreți ai de făcut acum?
- Fii atent la semnalele corpului tău: notează apariția reacțiilor cutanate, a simptomelor digestive sau a episoadelor de înroșire bruscă și identifică posibilii factori declanșatori (alimente, medicamente, înțepături de insecte, stres).
- Programează o consultație de specialitate la REGINA MARIA pentru evaluare alergologică sau dermatologică, mai ales dacă manifestările sunt recurente sau severe. Solicită investigațiile recomandate de medic (dozarea triptazei, biopsii sau teste genetice), pentru un diagnostic corect și complet.
👉 Programează-te pentru triptaza serică și obține rezultatul corect într-un timp scurt!
- Respectă planul de tratament și recomandările privind alimentația și evitarea factorilor declanșatori, pentru a reduce riscul de reacții severe.
- Asigură-te că ai la îndemână medicația de urgență, inclusiv adrenalina autoinjectabilă, dacă medicul ți-a indicat acest lucru.

Întrebări frecvente despre mastocitoză
Mastocitoza este ereditară?
În cele mai multe cazuri, mastocitoza nu este o boală ereditară care se transmite direct de la părinți la copii. Deși afecțiunea este cauzată de o mutație genetică, aceasta este de obicei o mutație somatică, adică apare spontan în celulele pacientului după concepție și nu este prezentă în celulele germinale.
Cum pot preveni crizele de șoc anafilactic în mastocitoză?
Prevenția se bazează pe identificarea și evitarea riguroasă a factorilor declanșatori care forțează eliberarea de mediatori chimici. Este vital să porți mereu o trusă de urgență cu adrenalină autoinjectabilă și să informezi medicii despre diagnosticul tău înainte de orice intervenție chirurgicală sau investigație cu substanță de contrast.
Mastocitoza este cancer?
Mastocitoza este clasificată ca o neoplazie mieloproliferativă, ceea ce înseamnă o creștere anormală a celulelor în măduvă. Totuși, majoritatea pacienților au forme indolente (blânde) care nu scurtează speranța de viață. Formele agresive sau leucemia cu mastocite sunt considerate maligne, dar acestea reprezintă un procent foarte mic din totalul cazurilor.
Mastocitoza se vindecă?
În prezent, nu există un tratament care să elimine complet boala la adulți, aceasta fiind considerată o afecțiune cronică gestionabilă. Excepția notabilă este mastocitoza la copii, unde formele cutanate pot prezenta o regresie spontană a simptomelor și a leziunilor până la intrarea în perioada pubertății.
Ce indică o valoare crescută pentru triptaza serică?
Nivelul de triptază serică este cel mai important marker în diagnosticarea și monitorizarea bolii. O valoare constant mărită (peste 20 ng/mL) sugerează o acumulare sistemică de mastocite.
⚠️ Disclaimer: Acest articol este cu titlu informativ și nu constituie o recomandare medicală. Informațiile din acest material nu înlocuiesc consultul medical sau recomandările specialistului.
Bibliografie:
- Allergy and Asthma Network, What Are Mast Cell Diseases?, https://allergyasthmanetwork.org/mast-cell-diseases/
- American Academy of Allergy, Asthma & Immunology (AAAAI), Mastocytosis Definition and Symptoms, https://www.aaaai.org/conditions-treatments/related-conditions/systemic-mastocytosis
- Mayo Clinic, Mastocytosis - Diagnosis and Treatment, https://www.mayoclinic.org/diseases-conditions/systemic-mastocytosis/diagnosis-treatment/drc-20450478



